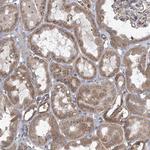
COPB2 Antibody in Immunohistochemistry (Paraffin) (IHC (P))

Search
Invitrogen
COPB2 Polyclonal Antibody
{{$productOrderCtrl.translations['antibody.pdp.commerceCard.promotion.promotions']}}
{{$productOrderCtrl.translations['antibody.pdp.commerceCard.promotion.viewpromo']}}
{{$productOrderCtrl.translations['antibody.pdp.commerceCard.promotion.promocode']}}: {{promo.promoCode}} {{promo.promoTitle}} {{promo.promoDescription}}. {{$productOrderCtrl.translations['antibody.pdp.commerceCard.promotion.learnmore']}}
产品信息
PA5-57852
宿主/亚型
分类
类型
抗原
偶联物
形式
浓度
规格
保存条件
运输条件
RRID
产品详细信息
Immunogen sequence: VALGYDEGSI IVKLGREEPA MSMDANGKII WAKHSEVQQA NLKAMGDAEI KDGERLPLAV KDMGSCEIYP QTIQHNPNGR FVVVCGDGEY IIYTA
Highest antigen sequence identity to the following orthologs: Mouse - 99%, Rat - 99%.
靶标信息
The coatomer is a cytosolic protein complex that binds to dilysine motifs and reversibly associates with Golgi non- clathrin-coated vesicles, which further mediate biosynthetic protein transport from the ER, via the Golgi up to the trans Golgi network. Coatomer complex is required for budding from Golgi membranes, and is essential for the retrograde Golgi-to-ER transport of dilysine-tagged proteins. In mammals, the coatomer can only be recruited by membranes associated to ADP-ribosylation factors (ARFs), which are small GTP-binding proteins; the complex also influences the Golgi structural integrity, as well as the processing, activity, and endocytic recycling of LDL receptors.
仅用于科研。不用于诊断过程。未经明确授权不得转售。